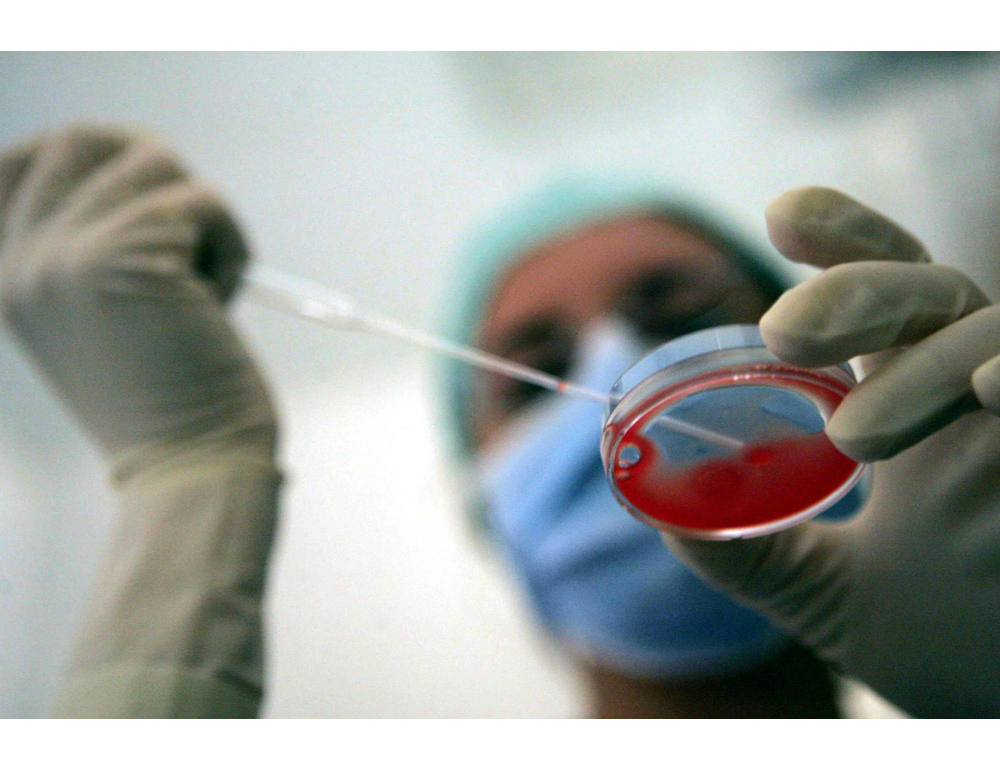

(ANSA) – TORINO, 15 DIC – Un’alleanza con Liguria e Lazio per acquistare i gameti all’estero e fornire la procreazione medicalmente assistita eterologa anche in Piemonte. È una delle possibili strade da percorrere per superare l’impasse in cui si trovano le coppie piemontesi. La Regione dovrebbe infatti garantire la Pma dal momento che è prevista nei Lea, i livelli essenziali di assistenza, ma non può farlo, poiché in Italia non esiste una banca pubblica di gameti, né maschili né femminili, a cui gli ospedali possano rivolgersi per portare avanti le procedure. L’unica alternativa, dunque, è l’acquisto. A riportarlo è il quotidiano la Repubblica. Alcune regioni, come la Toscana, si sono attrezzate e partecipano da anni a bandi di acquisto di gameti, dove la spesa media, per un kit da sei ovociti, è di circa 3.500 euro. I costi però sono rilevanti, sia per chi deve recarsi lontano da casa per eseguire la procedura che per la Regione che si occupa dell’acquisto dei gameti. Nasce da qui la proposta, accolta con favore dell’assessore regionale alla Sanità del Piemonte, Federico Riboldi, di creare una gara di acquisto di gameti congiunta, insieme con Liguria e Lazio. L’idea di una federazione tra le regioni per l’acquisto dei gameti è stata avanzata da Paola Anserini, presidente della Società italiana di fertilità e sterilità e responsabile del centro di Fisiopatologia della riproduzione umana dell’ospedale San Martino di Genova. Si aggiunge l’ipotesi del "social freezing", la pratica per cui le donne in età fertile possono congelare i propri ovociti, per utilizzarli più avanti nel tempo per una gravidanza. "L’idea è che si possa utilizzare il social freezing anche per la fecondazione eterologa", suggerisce Anserini: la proposta è che le donne che decidono di congelare i propri ovuli, ne donino alcuni. (ANSA).
Piemonte cerca gameti per eterologa, idea è l’alleanza con altre regioni

Lascia un commento